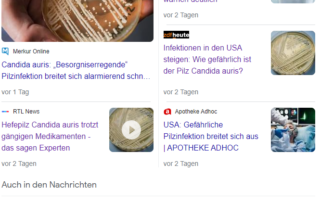
Der Hefepilz Candida auris in einer Petrischale, aufgenommen in einem Labor der Universität in Würzburg. Quelle: dpa

Gehirnchip-Tests nur für einen bestimmten Personenkreis / Neuralink
Quelle: https://www.golem.de/news/neuralink-gehirnchip-tests-nur-fuer-einen-bestimmten-personenkreis-2306-174681.html Das Gehirnchip-Unternehmen von Elon Musk hat seine Zulassung für klinische Tests an Menschen erhalten. Allerdings dürfen nur bestimmte Personen an der Studie teilnehmen. Die Testphase beim